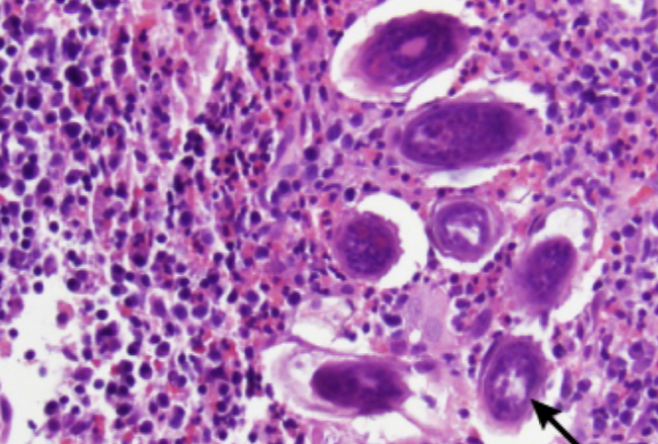

what is the MOA of desmopressin for hemophilia?
increases circualting VIII and endothelial protein secretion of vWF to stop bleeding
what CDs are on immature cortical T cells?
CD 4 and CD8
what hormone breaks TG into free fatty acids and glycerol in order to make glucose and ketone bodies ?
HSL
osteoblast function correlates with what lab vcalue?
ALkaline phosphatase
n-terminal peptide of type I collagen
calculate cumulative incidence
new diagnosis divided by those at risk (so take out the ones who already have the dx from the population)
v shaped branching of aspergillus
remember that mucor and rhozpus are at wide angles, not septate, ribon like

squatting during a tet spell does what?
increases systemic vascular resistance!!
you knew this!!
chronic granulomatous disease is deficient in what
at risk for what?
NADPH oxidase
catalase + orgnaisms like staph aurus, burkholderia, serratia, nocardia
aspergillus
in venous insuffeiciency leading to stasis dermatitis, what leads to the reddish brown discoleration?
hemosiderin deposition
pt’s with severe mitral regurg will develop what?
S3 due to large volume of regurgitant blood reentering the ventricle at mid-diastole
no S3 means it can’t be severe chronic mitral regurg
Bh4-Bh2 conversion in PKU requires what enzyme
dihydropterin reductase

if bleeding does’nt stop when you clamp the hepatoduodenal lgiament (which has portal vein in it) then where is the bleeding probably coming from?
IVC
what is responsible for the toelrance affect seen with a adrenerigc and beta adrenergic agonsits?
activcation of these receptors leads to arrestin binding and internalizaiont
the more these receptors are internalized, the mroe tolerant you become and need higher and higher doses ebcause theyre are fewer r available
people with liver disease and iron overload are more at risk for what infection?
vibrio vulnificus
what kind of cell killing leads to councilman bodies?
t cell mediated apoptosus
how did uworld describe marfans
tall with long UE and fingers
narrow face
slanted palprbael fissures
flat malar bones
small jaw
late systolic murmur at the apex due to myxamatous mitral degeneration–>MVP
giving a b blocker to a pt with HCM will do what?
decrease contraction of the Lv and HR
decrease murmur
increase LV volume
reduce outflow tract obstruction by INCREASING preload
improve sx
what causes this
schistosomiasis

transient recurrent pulmonary infiltrates and bronchiectasis is what dxz?
apergillus causing allergic bronchopulmonary aspergillosis
elevated procalcitonin indicates what?
low procalcitonin indicates what?
bacterial infection
viral infection
how does progesterone effect intestinal mobility?
decreases colonic smooth muscle activity and the gravid uterus can impede motion as well

what bacteria produce IgA protease?
n meningitidis, n gonhorrhea, strep pneumo, h flu
cleaves IgA at the hinge region making it ineefective (but its already a bad opsonizer, so does’nt reallt effect opsonization)
Main function is to help thebacteria stick to surfacs
tumor lysis syndrome
increases K, uric acid, phosphurs, LDH

atrial l-r shunts cause wide splt S2 and facilitate what?
paradoxical emobili